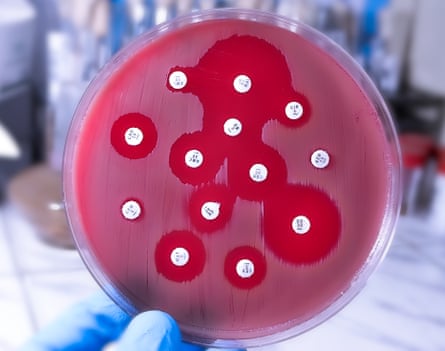

What we’re putting into our bodies can either nourish us, or make us ill. With that in mind, I wrote recently about the role of food consumption in terms of the risk of colon cancer. But what about food production?
Across the world, we are seeing the rise of cheap meat: largely driven by demand from a rising middle class who finally can afford beef, pork and chicken, which used to be out of reach, given their cost. Approximately 45% of global consumption growth is occurring in upper-middle-income countries including China, India, Brazil, Indonesia and the Philippines. Poultry is set to take an increasingly large share of that growth (projected to grow by 21% by 2034), because it is relatively cheap, widely acceptable and requires fewer resources per kilogram compared with beef or pork. By 2034, it is estimated that poultry will provide 45% of the protein consumed from all meat sources.
But this comes with costs. With limited land and intense time pressure, the solution in many countries has been to use antibiotics at scale. This isn’t just to treat illness, but also as a prophylactic to prevent disease in crowded conditions. And giving antibiotics causes livestock to grow faster, although scientists aren’t sure exactly why that is. All of this means that, unlike their use for humans – where antibiotics are almost always given to treat illness – their use in farming is much more widespread and indiscriminate. Studies tracking their use estimate that 73% of all antimicrobials sold globally are used in animals raised for food.
This enormous overuse is leading to a rise in antibiotic-resistant pathogens. For example, resistance to colistin, a “last-resort antibiotic”, first developed in E coli bacteria which then infected pigs. E coli was later found in pig farmers. All it takes is aeroplanes and global travel networks for these pathogens to spread globally. And now, colistin-resistant bacteria have been identified not only in hospitals in China, but across the world.
What does this mean for someone sitting in a GP clinic or a hospital in England or Scotland? It means that infections that were once easily treatable (think of ear infections, urinary tract infections or post-operative infections) become untreatable even after a dose of antibiotics. It means that surgeries such as caesarean sections, hip replacements and cancer therapies that rely on immune suppression all become riskier. And while new antibiotics are technically possible to develop, the pipeline is slow and costly. We have to preserve the arsenal we have.
The solutions to this problem can only come from changing global food production. To be fair, the UK has made significant progress in reducing antibiotics in farming. Sales of antibiotics for animals reared for food has dropped by 59% since 2014. The use of colistin is now effectively zero. The use of critically important antibiotics has dropped to less than 0.5% of all animal antibiotic sales. And research by several EU bodies suggested that after antibiotic use in farming was cut by nearly half between 2014 and 2021, antibiotic resistance in E coli across the bloc also began to decline.
But just focusing on the UK or EU is a drop in the bucket. Unless the large middle-income countries are part of the conversation on how meat is produced, we remain just as vulnerable to antibiotic resistance. The challenge is that moving towards different production practices takes more space and time: making meat even more expensive in countries with large populations can quickly trigger social unrest, political backlash and frustration. The health imperative is clear, but this needs to be balanced with concerns over food security, economics and public demand.
Climate scientists have long warned about the environmental costs of the current global food system, whether it’s methane emissions, biodiversity loss, or deforestation. But these effects often feel long-term and abstract, especially for people struggling with cost-of-living pressures or concerned with immediate healthcare access.
Antibiotic resistance is tangible. Almost everyone has taken antibiotics at some point, and we can imagine what would happen if their infection-clearing effect was suddenly switched off. Food production, health and climate are all connected. How pork is produced in China affects whether your child’s antibiotics work in Edinburgh. Whether a woman in Lagos survives a C-section is linked to how chickens are farmed in Brazil.
after newsletter promotion
Unless we confront these pervasive, world-spanning challenges, such as how our food is produced and how we use our current medications, we risk losing something precious: the ability to treat infections that we take for granted today.
-
Prof Devi Sridhar is chair of global public health at the University of Edinburgh